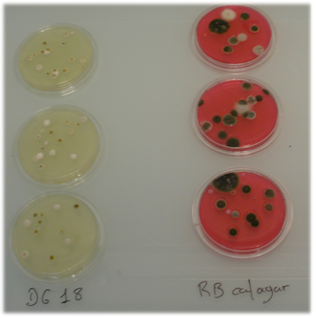

DICLORAN GLICEROL DG18 AGAR Recuento selectivo, máxima recuperación de hongos en alimentos con actividad de agua inferior a 0,95, (ISO 21527)
Recuento selectivo con máxima recuperación de hongos (Levaduras y Mohos) en alimentos con actividad de agua inferior a 0,95, según ISO 21527-2:2008.
COMPOSICIÓN
Digerido enzimático de caseína 5,00 g
Glucosa 10,00 g
Fosfato potásico 1,00 g
Sulfato de magnesio 0,50 g
Dicloran (2,6 dicloro-4-nitroanilina) 0,002 g
Cloranfenicol 0,10 g
Agar-agar 15,00 g
(Fórmula por litro)
pH final: ajustar a 5,6 ± 0,2
PREPARACIÓN
Disolver 31,6 g del medio en 1 litro de agua destilada que contenga 220 g de glicerol (SDA073). Calentar agitando hasta ebullición para su disolución. Autoclavar a 121 ºC durante 15 minutos.
PARA USO EXCLUSIVO EN LABORATORIO. MANTENGA EL BOTE BIEN CERRADO EN LUGAR SECO FRESCO Y OSCURO. AGITE EL BOTE ANTES DE USAR.
CODIGO: DMT228
CONTROL DE CALIDAD DEL MEDIO
Realizado en nuestro laboratorio; es prudente repetirlo en su laboratorio siempre que varíen las condiciones (más de 3 meses sin usar, tras desinfectar laboratorio, tras conservar a alta Tª, cuando adquiere aspectos extraños aunque no haya llegado la fecha de caducidad teórica de la etiqueta,…)
DESHIDRATADO: Polvo grueso, Crema PREPARADO: Estéril, Amarillo
CONTROL DE CRECIMIENTO CUANTITATIVO 3-5 días a temperatura ambiente (21-28°C aproximadamente) en oscuridad:
- Wallemia sebi MKTA 42694, Bueno, con respecto a SDA estandarizado*, recuento 95 %.
- Saccharomyces cerevisiae MKTA 9763, Correcto, con respecto a SDA estandarizado*, recuento 79 %.
- Aspergillus restrictus MKTA 42693, Bueno, con respecto a SDA estandarizado*, recuento 81 %.
- Escherichia coli MKTA 25922, Inhibido.
- Bacillus subtilis MKTA 6633, Inhibido.
* El que cumple con recuperación superior al 92-125% con respecto a cepas cuantitativas trazables a la cepa tipo. Incertidumbres detectadas entre todos los lotes a lo largo de un año (la mayoría de la incertidumbre se debe a la cepa y a la proporción de cepas acompañantes inoculadas, no al medio).
PRESENTACIÓN:
MEDIO DESHIDRATADO
NOTAS:
Medio ideal para la máxima recuperación de hongos (levaduras y mohos) en alimentos de muy baja actividad de agua. Las bacterias acompañantes son inhibidas por el cloranfenicol, antibacteriano de amplio espectro. Gracias al pH neutro, las células y esporas dañadas crecen sin problemas, de ahí su magnífica recuperación. El dicloran limita la invasión de la placa por mohos de crecimiento rápido. Pero la luz intensa lo hace inhibitorio!: No utilizar medios irradiados a dosis normales ni incubar fuera de estufas o armarios cerrados.
SIEMBRA
Sembrar en superficie 0,1 ml de muestra y su serie de diluciones decimales, extendiendo con un triángulo de vidrio. Esta siembra es ideal para máximo recuento de mohos, muy aerófilos. Sin embargo, para levaduras, se suelen obtener mejores resultados con siembra en masa, dada su capacidad fermentativa. En todo caso, una siembra duplicada (una placa en masa y otra en superficie) es ideal en cualquier medio para hongos donde se desee un recuento óptimo de levaduras y de mohos. Las Placas de Contacto se aplican sobre la superficie o se introducen en un aparato para control de aire. Incubar a 22 ºC aproximadamente, 3-5 días, ¡en total oscuridad!.
INTERPRETACIÓN
Contar todas las colonias (filamentosas, mohos; no filamentosas, levaduras).
Este es el medio Normalizado para control de mohos y levaduras en ALIMENTOS según Norma ISO 21527-2:2008
El usuario final es el único responsable de la eliminación de los microorganismos según la legislación medioambiental vigente. Autoclavar antes de desechar a la basura.
Si desea más información sobre nuestros MEDIO DICLORAN GLICEROL DG18 AGAR rellene nuestro formulario de contacto http://www.medioscultivo.com/contacto . O si lo prefiere póngase en contacto con nosotros a través de nuestro correo electrónico microkit@microkit.es o por teléfono en el nº 91-897 46 16
https://www.microkit.es/fichas/DICLORAN-GLICEROL-DG18-AGAR.pdf
